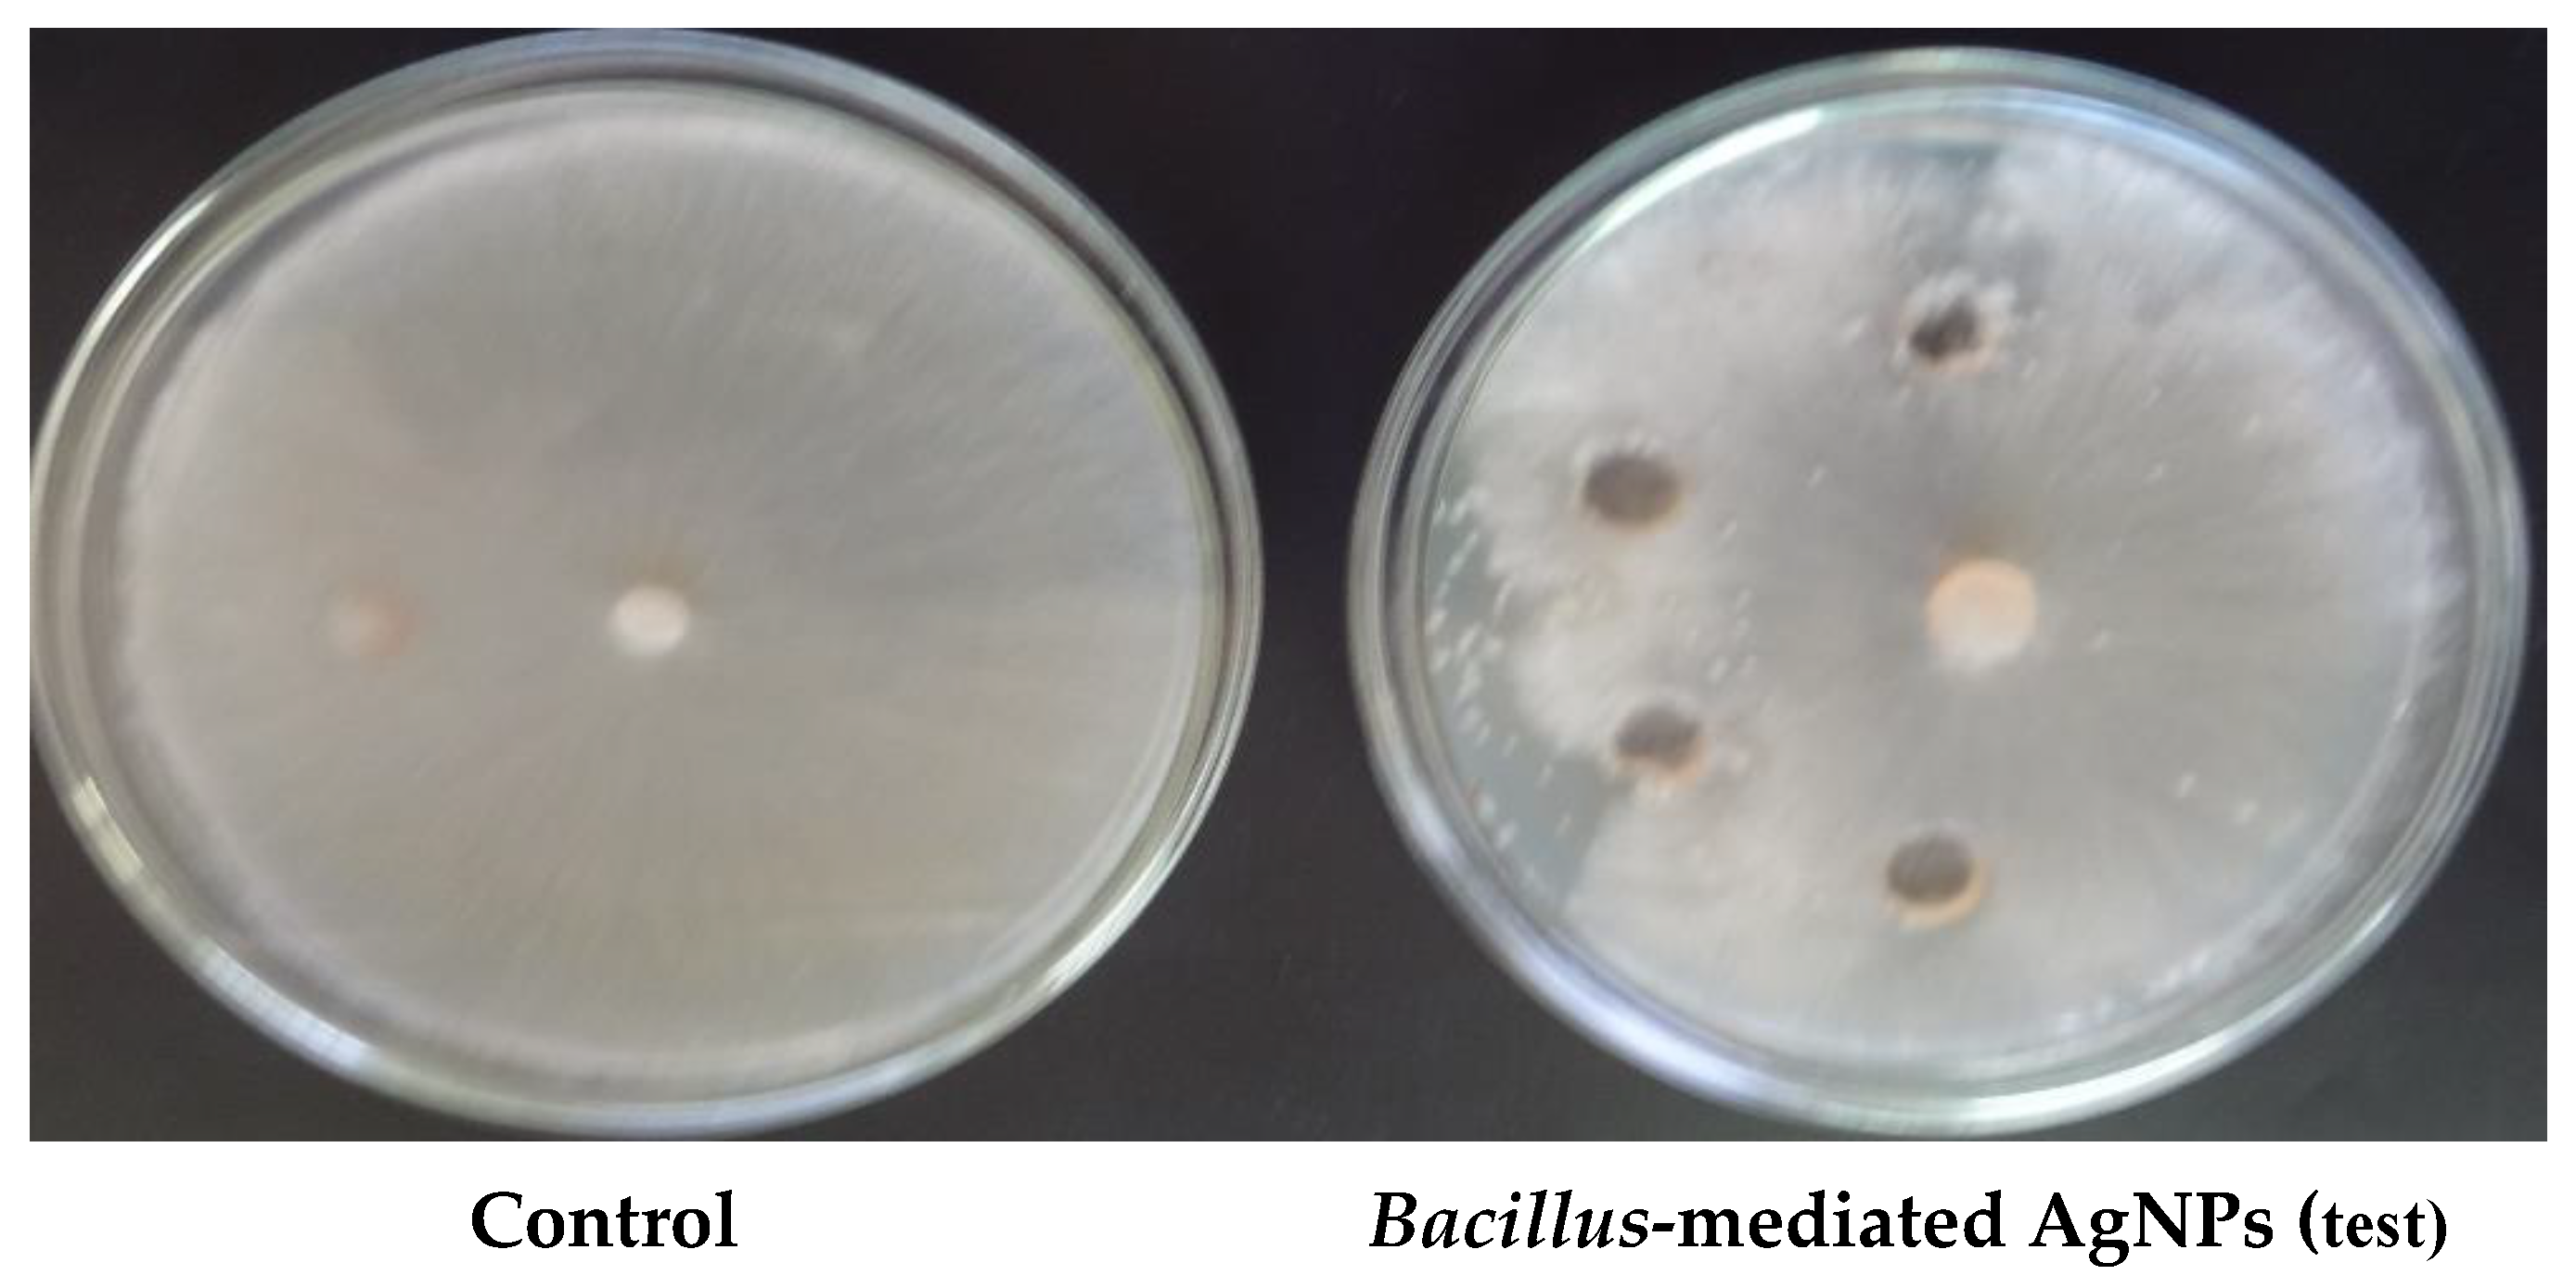
Antibiotics 10 01334 g004 550

Bacillus-Mediated Silver Nanoparticle Synthesis and Its Antagonistic Activity against Bacterial and Fungal Pathogens
Abstract
:1. Introduction
2. Methodological Analysis
2.1. Isolation of Rhizosphere Bacillus
2.2. Phenotypic Identification
2.3. Growth-Promoting Assay and Enzyme Activity
2.3.1. Growth-Promoting Characteristics of the Isolate (IAA Siderophore and Phosphate Solubilization)
IAA
Siderophore
Phosphate Solubilization
2.3.2. Enzyme-Synthesizing Characteristics of the Isolates (Protease, Lipase, Amylase, and Pectinase)
2.4. Synthesis of Silver Nanoparticles
2.5. Collection of Bacterial Samples
2.6. Collection of Fungal Samples
2.7. Antagonistic Activity
2.7.1. Antibacterial Study
2.7.2. Antifungal Study
2.8. Analytical Characterization
2.9. Instrumental Analysis for the Bacterial and Fungal Study
2.9.1. Confocal Microscopy for Bacterial Activity
2.9.2. High-Content Screening Study for Fungal Activity
2.9.3. Compound Microscopy Study for Fungal Activity
3. Results
3.1. Phenotypic Study
3.1.1. Growth-Promoting and Enzymatic Characteristics of the Isolate
3.1.2. Enzymatic Characteristics of the Isolates
3.2. Biosynthesis of Silver Nanoparticles
3.3. Antibacterial Activity
3.4. Antifungal Activity
3.5. UV Absorption Spectra
3.6. Particle Size Analyzer
3.7. XRD
3.8. Scanning Electron Microscopy
3.8.1. Atomic Force Microscopy
3.8.2. Instrumental Analysis for Bacterial and Fungal Study
Confocal Microscopy for Bacterial Activity
3.8.3. Compound Microscopy for Fungal Activity
3.8.4. Applications of Synthesized Bs-AgNPs in Treating Leaves Affected by Sheath Blight Disease
3.8.5. Growth Promotion of Oryza sativa Seeds
4. Discussion
5. Conclusions
Author Contributions
Funding
Institutional Review Board Statement
Informed Consent Statement
Data Availability Statement
Acknowledgments
Conflicts of Interest
References
- Beyene, H.D.; Werkneh, A.A.; Bezabh, H.K.; Ambaye, T.G. Synthesis paradigm and applications of silver nanoparticles (AgNPs), a review. Sustain. Mater. Technol. 2017, 13, 18–23. [Google Scholar] [CrossRef]
- Chen, X.; Schluesener, H.J. Nanosilver: A nanoproduct in medical application. Toxicol. Lett. 2008, 176, 1–12. [Google Scholar] [CrossRef]
- Mallevre, F.; Alba, C.; Milne, C.; Gillespie, S.; Fernandes, T.F.; Aspray, T.J. Toxicity Testing of Pristine and Aged Silver Nanoparticles in Real Wastewaters Using Bioluminescent Pseudomonas putida. Nanomaterials 2016, 6, 49. [Google Scholar] [CrossRef]
- Franci, G.; Falanga, A.; Galdiero, S.; Palomba, L.; Rai, M.; Morelli, G.; Galdiero, M. Silver Nanoparticles as Potential Antibacterial Agents. Molecules 2015, 20, 8856–8874. [Google Scholar] [CrossRef] [Green Version]
- Abirami, K.; Maghimaa, M. Phytochemical Screening and Bioactivity of Zingiber Officinale to Combat the Multidrug-Resistant Bacterial Pathogens Using Foldscope. Uttar Pradesh J. Zool. 2019, 11, 67–74. [Google Scholar]
- Vakayil, R.; Kabeerdass, N.; Kuppusamy, A.; Mathanmohun, M. Phytochemical screening and antibacterial properties of Punica granatum extracts against gastrointestinal infection an in-vitro study. Uttar Pradesh J. Zool. 2019, 26, 25–32. [Google Scholar]
- Acharya, P.; Jayaprakasha, G.K.; Crosby, K.M.; Jifon, J.L.; Patil, B.S. Nanoparticle-Mediated Seed Priming Improves Germination, Growth, Yield, and Quality of Watermelons (Citrullus lanatus) at multi-locations in Texas. Sci. Rep. 2020, 10, 5037. [Google Scholar] [CrossRef] [Green Version]
- Akanbi-Gada, M.A.; Ogunkunle, C.O.; Vishwakarma, V.; Viswanathan, K.; Fatoba, P.O. Phytotoxicity of nano-zinc oxide to tomato plant (Solanum lycopersicum L.): Zn uptake, stress enzymes response and influence on non-enzymatic antioxidants in fruits. Environ. Technol. Innov. 2019, 14, 100325. [Google Scholar] [CrossRef]
- Płaza, G.A.; Chojniak, J.; Mendrek, B.; Trzebicka, B.; Kvitek, L.; Panacek, A.; Prucek, R.; Zboril, R.; Paraszkiewicz, K.; Bernat, P. Synthesis of silver nanoparticles by Bacillus subtilis T-1 growing on agro-industrial wastes and producing biosurfactant. IET Nanobiotechnol. 2016, 10, 62–68. [Google Scholar] [CrossRef]
- Elias, E.H.; Flynn, R.; Idowu, O.J.; Reyes, J.; Sanogo, S.; Schutte, B.J.; Smith, R.; Steele, C.; Sutherland, C. Crop Vulnerability to Weather and Climate Risk: Analysis of Interacting Systems and Adaptation Efficacy for Sustainable Crop Production. Sustainability 2019, 11, 6619. [Google Scholar] [CrossRef] [Green Version]
- Sharifi, M.; Faryabi, K.; Talaei, A.J.; Shekha, M.S.; Ale-Ebrahim, M.; Salihi, A.; Nanakali, N.M.Q.; Aziz, F.M.; Rasti, B.; Hasan, A.; et al. Antioxidant properties of gold nanozyme: A review. J. Mol. Liq. 2020, 297, 112004. [Google Scholar] [CrossRef]
- Maghimaa, M.; Alharbi, S.A. Green synthesis of silver nanoparticles from Curcuma longa L. and coating on the cotton fabrics for antimicrobial applications and wound healing activity. J. Photochem. Photobiol. B Biol. 2020, 204, 111806. [Google Scholar] [CrossRef]
- Ansari, S.; Bari, A.; Ullah, R.; Mathanmohun, M.; Veeraraghavan, V.P.; Sun, Z. Gold nanoparticles synthesized with Smilax glabra rhizome modulates the anti-obesity parameters in high-fat diet and streptozotocin induced obese diabetes rat model. J. Photochem. Photobiol. B Biol. 2019, 201, 111643. [Google Scholar] [CrossRef]
- Shaik, M.R.; Ali, Z.J.Q.; Khan, M.; Kuniyil, M.; Assal, M.E.; Alkhathlan, H.Z.; Al-Warthan, A.; Siddiqui, M.R.H.; Khan, M.; Adil, S.F. Green Synthesis and Characterization of Palladium Nanoparticles Using Origanum vulgare L. Extract and Their Catalytic Activity. Molecules 2017, 22, 165. [Google Scholar] [CrossRef]
- Anasane, N.; Golinska, P.; Wypij, M.; Rathod, D.; Dahm, H.; Rai, M. Acidophilic actinobacteria synthesised silver nanoparticles showed remarkable activity against fungi-causing superficial mycoses in humans. Mycoses 2015, 59, 157–166. [Google Scholar] [CrossRef]
- Sharma, D.; Kanchi, S.; Bisetty, K. Biogenic synthesis of nanoparticles: A review. Arab. J. Chem. 2019, 12, 3576–3600. [Google Scholar] [CrossRef] [Green Version]
- Kabeerdass, N.; Krishnamoorthy, S.; Anbazhagan, M.; Srinivasan, R.; Nachimuthu, S.; Rajendran, M.; Mathanmohun, M. Screening, detection and antimicrobial susceptibility of multi-drug resistant pathogens from the clinical specimens. Mater. Today Proc. 2021, 47, 461–467. [Google Scholar] [CrossRef]
- Vakayil, R.; Krishnamoorthy, S.; Gnanendra, S.; Senthil Kumar, N.; Ramasamy, S.; Mathanmohun, M. Screening And Identi-fication Of Multi-Drug Resistance Nosocomial Infection, Isolates From Clinical Specimen: A Cross-Sectional Study. Plant Arch. 2020, 20, 7247–7251. [Google Scholar]
- Wang, L.; He, D.; Gao, S.; Wang, D.; Xue, B.; Yokoyama, K. Biosynthesis of silver nanoparticles by the fungus Arthroderma fulvum and its antifungal activity against genera of Candida, Aspergillus and Fusarium. Int. J. Nanomed. 2016, 11, 1899–1906. [Google Scholar] [CrossRef] [Green Version]
- Kubyshkin, A.; Chegodar, D.; Katsev, A.; Petrosyan, A.; Krivorutchenko, Y.; Postnikova, O. Antimicrobial Effects of Silver Nanoparticles Stabilized in Solution by Sodium Alginate. Biochem. Mol. Biol. J. 2016, 2, 13. [Google Scholar] [CrossRef] [Green Version]
- Vakayil R, Kabeerdass N, Srinivasan R, Shanmugam G, Ramasamy S, Mathanmohun M (2021) Invitro and insilico studies on antibacterial potentials of phytochemical extracts. Mater. Today Proc. 2021, 47, 453–460. [CrossRef]
- Wypij, M.; Czarnecka, J.; Dahm, H.; Rai, M.; Golinska, P. Silver nanoparticles from Pilimelia columellifera subsp. pallida SL19 strain demonstrated antifungal activity against fungi causing superficial mycoses. J. Basic Microbiol. 2017, 57, 793–800. [Google Scholar] [CrossRef]
- Espenti, C.S.; Rao, K.K. Bio-synthesis and characterization of silver nanoparticles using Terminalia chebula leaf extract and evaluation of its antimicrobial potential. Mater. Lett. 2016, 174, 129–133. [Google Scholar] [CrossRef]
- Adisa, I.O.; Pullagurala, V.L.R.; Rawat, S.; Hernandez-Viezcas, J.A.; Dimkpa, C.O.; Elmer, W.H.; White, J.C.; Peralta-Videa, J.R.; Gardea-Torresdey, J.L. Role of Cerium Compounds in Fusarium Wilt Suppression and Growth Enhancement in Tomato (Solanum lycopersicum). J. Agric. Food Chem. 2018, 66, 5959–5970. [Google Scholar] [CrossRef]
- Chen, Y.-E.; Mao, H.-T.; Wu, N.; Din, A.M.U.; Khan, A.; Zhang, H.-Y.; Yuan, S. Salicylic Acid Protects Photosystem II by Alleviating Photoinhibition in Arabidopsis thaliana under High Light. Int. J. Mol. Sci. 2020, 21, 1229. [Google Scholar] [CrossRef] [PubMed] [Green Version]
- Gohari, G.; Mohammadi, A.; Akbari, A.; Panahirad, S.; Dadpour, M.R.; Fotopoulos, V.; Kimura, S. Titanium dioxide nanoparticles (TiO2 NPs) promote growth and ameliorate salinity stress effects on essential oil profile and biochemical attributes of Dracocephalum moldavica. Sci. Rep. 2020, 10, 912. [Google Scholar] [CrossRef]
- Vakayil, R.; Muruganantham, S.; Kabeerdass, N.; Rajendran, M.; Palve, A.M.; Ramasamy, S.; Alahmadi, T.A.; Almoallim, H.S.; Manikandan, V.; Mathanmohun, M. Acorus calamus-zinc oxide nanoparticle coated cotton fabrics shows antimicrobial and cytotoxic activities against skin cancer cells. Process. Biochem. 2021, 111, 1–8. [Google Scholar] [CrossRef]
- Iqbal, M.; Asif, S.; Ilyas, N.; Raja, N.I.; Hussain, M.; Shabir, S.; Faz, M.N.A.; Rauf, A. Effect of plant derived smoke on germination andpost germination expression of wheat (Triticum aestivum L.). Am. J. Plant Sci. 2016, 7, 806–813. [Google Scholar] [CrossRef] [Green Version]
- Huang, H.; Ullah, F.; Zhou, D.-X.; Yi, M.; Zhao, Y. Mechanisms of ROS Regulation of Plant Development and Stress Responses. Front. Plant Sci. 2019, 10, 800. [Google Scholar] [CrossRef]
- Jordan, J.T.; Oates, R.; Subbiah, S.; Payton, P.R.; Singh, K.P.; Shah, S.A.; Green, M.J.; Klein, D.M.; Cañas-Carrell, J.E. Carbon nanotubes affect early growth, flowering time and phytohormones in tomato. Chemosphere 2020, 256, 127042. [Google Scholar] [CrossRef]
- Juárez-Maldonado, A.; Ortega-Ortíz, H.; Morales-Díaz, A.B.; González-Morales, S.; Morelos-Moreno, Á.; Sandoval-Rangel, A.; Cadenas-Pliego, G.; Benavides-Mendoza, A. Nanoparticles and Nanomaterials as Plant Biostimulants. Int. J. Mol. Sci. 2019, 20, 162. [Google Scholar] [CrossRef] [Green Version]
- Sivakumar, K.; Ananda kumar, D.; Nivedhitha, K.; Maghimaa, M. Effect of AM Fungi and PSB inoculation on the per cent root colonization, AM fungal spore number and PSB population in the rhizosphere soils of brinjal (Solanum melongena L.). MCAS J. Res. 2018, 4, 53–58. [Google Scholar]
- Vakayil, R.; Krishnamoorthy, S.; Anbazhagan, M.; Senthil Kumar, N.; Mathanmohun, M. Antibacterial Potential of Acorus Calamus Extracts Against the Multi-Drug Resistant Nosocomial Pathogens. Uttar Pradesh J. Zool. 2021, 24, 144–150. [Google Scholar]
- Vakayil, R.; Anbazhagan, M.; Shanmugam, G.; Ramasamy, S.; Mathanmohun, M. Molecular docking and in vitro analysis of phytoextracts from B. serrata for antibacterial activities. Bioinformation 2021, 17, 667–672. [Google Scholar] [CrossRef]
- Vakayil, R.; Abdul Nazeer, T.; Mathanmohun, M. Evaluation of the Antimicrobial Activity of Extracts from Acorus calamus Rhizome against Multidrug-resistant Nosocomial Pathogens. Res. J. Agric. Sci. 2021, 12, 1613–1617. [Google Scholar]
- Khan, M.N.; AlSolami, M.A.; Basahi, R.A.; Siddiqui, M.; Al-Huqail, A.A.; Abbas, Z.K.; Siddiqui, Z.; Ali, H.M.; Khan, F. Nitric oxide is involved in nano-titanium dioxide-induced activation of antioxidant defense system and accumulation of osmolytes under water-deficit stress in Vicia faba L. Ecotoxicol. Environ. Saf. 2020, 190, 110152. [Google Scholar] [CrossRef]
- Usman, M.; Farooq, M.; Wakeel, A.; Nawaz, A.; Alam Cheema, S.A.; Rehman, H.U.; Ashraf, I.; Sanaullah, M. Nanotechnology in agriculture: Current status, challenges and future opportunities. Sci. Total Environ. 2020, 721, 137778. [Google Scholar] [CrossRef]
- Sotoodehnia-Korani, S.; Iranbakhsh, A.; Ebadi, M.; Majd, A.; Ardebili, Z.O. Selenium nanoparticles induced variations in growth, morphology, anatomy, biochemistry, gene expression, and epigenetic DNA methylation in Capsicum annuum; an in vitro study. Environ. Pollut. 2020, 265, 114727. [Google Scholar] [CrossRef]
- Servin, A.D.; White, J.C. Nanotechnology in agriculture: Next steps for understanding engineered nanoparticle exposure and risk. NanoImpact 2016, 1, 9–12. [Google Scholar] [CrossRef]
- Moradbeygi, H.; Jamei, R.; Heidari, R.; Darvishzadeh, R. Investigating the enzymatic and non-enzymatic antioxidant defense by applying iron oxide nanoparticles in Dracocephalum moldavica L. plant under salinity stress. Sci. Hortic. 2020, 272, 109537. [Google Scholar] [CrossRef]
- Lv, J.; Christie, P.; Zhang, S. Uptake, translocation, and transformation of metal-based nanoparticles in plants: Recent advances and methodological challenges. Environ. Sci. Nano 2019, 6, 41–59. [Google Scholar] [CrossRef]
- Rathod, D.; Golinska, P.; Wypij, M.; Dahm, H.; Rai, M. A new report of Nocardiopsis valliformis strain OT1 from alkaline Lonar crater of India and its use in synthesis of silver nanoparticles with special reference to evaluation of antibacterial activity and cytotoxicity. Med. Microbiol. Immunol. 2016, 205, 435–447. [Google Scholar] [CrossRef] [Green Version]
- Mallmann, E.J.J.; Cunha, F.A.; Castro, B.N.M.F.; Maciel, A.M.; Menezes, E.A.; Fechine, P.B.A. Antifungal activity of silver nanoparticles obtained by green synthesis. Rev. Inst. Med. Trop. Sao Paulo 2015, 57, 165–167. [Google Scholar] [CrossRef]
- Kamran, U.; Bhatti, H.N.; Iqbal, M.; Jamil, S.; Zahid, M. Biogenic synthesis, characterization and investigation of photocatalytic and antimicrobial activity of manganese nanoparticles synthesized from Cinnamomum verum bark extract. J. Mol. Struct. 2019, 1179, 532–539. [Google Scholar] [CrossRef]
- Rodrigues, M.C.; Rolim, W.R.; Viana, M.M.; Souza, T.R.; Gonçalves, F.; Tanaka, C.J.; Bueno-Silva, B.; Seabra, A.B. Biogenic synthesis and antimicrobial activity of silica-coated silver nanoparticles for esthetic dental applications. J. Dent. 2020, 96, 103327. [Google Scholar] [CrossRef]
- Hsueh, Y.-H.; Lin, K.-S.; Ke, W.-J.; Hsieh, C.-T.; Chiang, C.-L.; Tzou, D.-Y.; Liu, S.-T. The Antimicrobial Properties of Silver Nanoparticles in Bacillus subtilis Are Mediated by Released Ag+ Ions. PLoS ONE 2015, 10, e0144306. [Google Scholar] [CrossRef] [Green Version]
- Baburam, S.; Ramasamy, S.; Shanmugam, G.; Mathanmohun, M. Quorum Sensing Inhibitory Potential and Molecular Docking Studies of Phyllanthus emblica Phytochemicals Against Pseudomonas aeruginosa. Appl. Biochem. Biotechnol. 2021, 1–11. [Google Scholar] [CrossRef]

| S.No. | Isolates | IAA | Siderophore | Phosphate Solubilization |
|---|---|---|---|---|
| 1. | mn1–3 | Negative | Negative | Negative |
| 2. | mn6–12 | Negative | Negative | Negative |
| 3. | mn13–27 | Positive | Positive | Positive |
| S.No. | Isolates | Zone of Inhibition | |||
|---|---|---|---|---|---|
| Protease | Amylase | Pectinase | Cellulase | ||
| 1. | mn1 | 11 mm | 7 mm | Nil | Nil |
| 2. | mn3 | 10 mm | 10 mm | Nil | 5 mm |
| 3. | mn4 | 10 mm | Nil | 5 mm | Nil |
| 4. | mn5, 6, 8 | 10 mm | Nil | Nil | Nil |
| 5. | mn9, 23 | 10 mm | 6 mm | Nil | Nil |
| 6. | mn10 | Nil | 9 mm | Nil | Nil |
| 7. | mn11 | 13 mm | Nil | Nil | Nil |
| 8. | mn12 | 5 mm | 10 mm | Nil | Nil |
| 9. | mn15 | 7 mm | 5 mm | Nil | Nil |
| 10 | mn16 | 8 mm | 11 mm | Nil | Nil |
| 11. | mn14 | 17 mm | 16 mm | 16 mm | 19 mm |
| 12. | mn20 | 3 mm | Nil | Nil | Nil |
| 13. | mn21 | 4 mm | Nil | Nil | Nil |
| 14. | mn2, 7, 13, 19, 17, 18, 22, 24, 25, 26, 27 | Nil | Nil | Nil | Nil |
| S. No. | Human Pathogen | Inhibition Zome (mm) of Bs-AgNPs against Human Pathogens | Inhibition Zone (mm) of Tetracycline (Control) against Human Pathogens | ||||||||||||||
|---|---|---|---|---|---|---|---|---|---|---|---|---|---|---|---|---|---|
| 5 µL | 10 µL | 20 µL | 30 µL | 40 µL | 50 µL | 60 µL | 70 µL | 5 µL | 10 µL | 20 µL | 30 µL | 40 µL | 50 µL | 60 µL | 70 µL | ||
| 1. | S. typhi | 5 ± 0.25 | 5 ± 0.25 | 5 ± 0.25 | 5 ± 0.25 | 6 ± 0.25 | 6 ± 0.25 | 6 ± 0.25 | 6 ± 0.25 | 6 ± 0.25 | 6 ± 0.25 | 6 ± 0.25 | 6 ± 0.25 | 6 ± 0.25 | 6 ± 0.25 | 6 ± 0.25 | 6 ± 0.25 |
| 2. | S. viridans | 15 ± 0.25 | 16 ± 0.25 | 16 ± 0.25 | 16 ± 0.25 | 16.9 ± 0.25 | 20 ± 0.25 | 17.5 ± 0.25 | 20 ± 0.25 | 15 ± 0.25 | 16 ± 0.25 | 16 ± 0.25 | 16 ± 0.25 | 16.9 ± 0.25 | 16 ± 0.25 | 17.5 ± 0.25 | 18 ± 0.25 |
| 3. | S. aureus | 10 ± 0.25 | 11 ± 0.25 | 12 ± 0.25 | 15 ± 0.25 | 15 ± 0.25 | 15 ± 0.25 | 15 ± 0.25 | 18 ± 0.25 | 10 ± 0.25 | 11 ± 0.25 | 12 ± 0.25 | 13 ± 0.25 | 16 ± 0.25 | 17 ± 0.25 | 15 ± 0.25 | 17 ± 0.25 |
| 4. | S. epidermis | 6.8 ± 0.25 | 6.8 ± 0.25 | 8 ± 0.25 | 7..2 ± 0.25 | 7.2 ± 0.25 | 7.8. ± 0.25 | 8.3 ± 0.25 | 8.3 ± 0.25 | 6.8 ± 0.25 | 6.8 ± 0.25 | 6.8 ± 0.25 | 7 ± 0.25 | 7.2 ± 0.25 | 7.2 ± 0.25 | 8.3 ± 0.25 | 8.3 ± 0.25 |
| 5. | C. albicans | 10 ± 0.25 | 12 ± 0.25 | 14 ± 0.25 | 15 ± 0.25 | 16 ± 0.25 | 18 ± 0.25 | 19 ± 0.25 | 18 ± 0.25 | 10 ± 0.25 | 12 ± 0.25 | 14 ± 0.25 | 15 ± 0.25 | 16 ± 0.25 | 16 ± 0.25 | 19 ± 0.25 | 18 ± 0.25 |
| 6. | K. pneumoniae | 6 ± 0.25 | 6 ± 0.25 | 6 ± 0.25 | 6 ± 0.25 | 7 ± 0.25 | 8 ± 0.25 | 9 ± 0.25 | 9 ± 0.25 | 6 ± 0.25 | 6 ± 0.25 | 6 ± 0.25 | 6 ± 0.25 | 6 ± 0.25 | 6 ± 0.25 | 9 ± 0.25 | 9 ± 0.25 |
| 7. | P. aeruginosa | 9 ± 0.25 | 12 ± 0.25 | 12 ± 0.25 | 14 ± 0.25 | 15 ± 0.25 | 15 ± 0.25 | 16 ± 0.25 | 15 ± 0.25 | 9 ± 0.25 | 12 ± 0.25 | 12 ± 0.25 | 14 ± 0.25 | 15 ± 0.25 | 15 ± 0.25 | 16 ± 0.25 | 14 ± 0.25 |
| 8. | B.cereus | 12 ± 0.25 | 13 ± 0.25 | 13 ± 0.25 | 13 ± 0.25 | 14 ± 0.25 | 14 ± 0.25 | 16 ± 0.25 | 15 ± 0.25 | 12 ± 0.25 | 12 ± 0.25 | 12 ± 0.25 | 13 ± 0.25 | 14 ± 0.25 | 14 ± 0.25 | 16 ± 0.25 | 15 ± 0.25 |
| 9. | E. coli | 10 ± 0.25 | 12 ± 0.25 | 13 ± 0.25 | 14 ± 0.25 | 14 ± 0.25 | 14 ± 0.25 | 15 ± 0.25 | 15 ± 0.25 | 10 ± 0.25 | 12 ± 0.25 | 13 ± 0.25 | 13 ± 0.25 | 14 ± 0.25 | 14 ± 0.25 | 15 ± 0.25 | 14 ± 0.25 |
| S.No. | Isolates of Bacillus sp. | Zone of Inhibition in mm | ||
|---|---|---|---|---|
| R. solani | M. phaseolina | S. rolfsii | ||
| 1. | mn1 | 6.5 ± 0.25 | 9 ± 0.25 | 7 ± 0.25 |
| 2. | mn2 | 7.2 ± 0.25 | Nil | Nil |
| 3. | mn3 | 4.5 ± 0.25 | Nil | Nil |
| 4. | mn4 | 4.5 ± 0.25 | Nil | Nil |
| 5. | mn5, 8 | 6.0 ± 0.25 | Nil | Nil |
| 6. | mn6 | 6.0 ± 0.25 | 7 ± 0.25 | Nil |
| 7. | mn7, 27 | 7.0 ± 0.25 | Nil | Nil |
| 8. | mn9 | 11.0 ± 0.25 | Nil | Nil |
| 9. | mn10 | 15.0 ± 0.25 | 9 ± 0.25 | Nil |
| 10. | mn11 | 12.0 ± 0.25 | Nil | 5 ± 0.25 |
| 11. | mn12 | 20.0 ± 0.25 | 6 ± 0.25 | 9 ± 0.25 |
| 12. | mn13 | 19.0 ± 0.25 | 8 ± 0.25 | Nil |
| 13. | mn14 | 23.0 ± 0.25 | 9 ± 0.25 | 6 ± 0.25 |
| 14. | mn15 | 17.0 ± 0.25 | 5 ± 0.25 | 7 ± 0.25 |
| 15. | mn16 | 19.0 ± 0.25 | Nil | 11 ± 0.25 |
| 16. | mn17 | 11.0 ± 0.25 | Nil | Nil |
| 17. | mn19 | 8.0 ± 0.25 | Nil | Nil |
| 18. | mn20 | 11.0 ± 0.25 | Nil | Nil |
| 19. | mn18, 21, 22, 23, 24, 25 | 9.0 ± 0.25 | Nil | Nil |
| 20. | mn24, 26 | 8.0 ± 0.25 | Nil | Nil |
| S.No. | Concentration | Inhibition Zone in mm | ||||||||||
|---|---|---|---|---|---|---|---|---|---|---|---|---|
| 5 µL | 10 µL | 20 µL | 30 µL | 40 µL | 50 µL | 60 µL | 70 µL | 80 µL | 90 µL | 100 µL | ||
| 1. | Bacillus-mediated AgNPs (Bs-AgNPs) | 6 ± 0.25 | 7 ± 0.25 | 8 ± 0.25 | 9 ± 0.25 | 9 ± 0.25 | 10.5 ± 0.25 | 15 ± 0.25 | 15 ± 0.25 | 14 ± 0.25 | 15.5 ± 0.25 | 20 ± 0.25 |
| 2. | Carbendazim | 5 ± 0.25 | 4 ± 0.25 | 4 ± 0.25 | 5 ± 0.25 | 5 ± 0.25 | 7 ± 0.25 | 13 ± 0.25 | 13 ± 0.25 | 14 ± 0.25 | 14 ± 0.25 | 15± 0.25 |
| Diseased Leaf Sample | Treatment with Bs-AgNPs (Lesion Length) | Treatment with Fungicide (Carbendazim) (Lesion Length) |
|---|---|---|
| Diseased sample leaf 1 | 4.6 cm | 8 cm |
| Diseased Sample leaf 2 | 3.2 cm | 6 cm |
| Diseased sample leaf3 | Nil | 3.1 cm |
| S.No. | Treatment | Germination (%) | Root Length(cm) | Shoot Length (cm) | Dry Weight (g) | Vigor Index |
|---|---|---|---|---|---|---|
| 1. | Distilled water (control) | 100 | 1.5 | 1.54 | 0.0203 | 1552.8 |
| 2. | Bs-AgNPs (Bacillus mediated AgNPs | 90 | 5.42 | 2.08 | 0.0399 | 2415.6 |
Publisher’s Note: MDPI stays neutral with regard to jurisdictional claims in published maps and institutional affiliations. |
© 2021 by the authors. Licensee MDPI, Basel, Switzerland. This article is an open access article distributed under the terms and conditions of the Creative Commons Attribution (CC BY) license (https://creativecommons.org/licenses/by/4.0/).
Share and Cite
Kabeerdass, N.; Al Otaibi, A.; Rajendran, M.; Manikandan, A.; Kashmery, H.A.; Rahman, M.M.; Madhu, P.; Khan, A.; Asiri, A.M.; Mathanmohun, M. Bacillus-Mediated Silver Nanoparticle Synthesis and Its Antagonistic Activity against Bacterial and Fungal Pathogens. Antibiotics 2021, 10, 1334. https://doi.org/10.3390/antibiotics10111334
Kabeerdass N, Al Otaibi A, Rajendran M, Manikandan A, Kashmery HA, Rahman MM, Madhu P, Khan A, Asiri AM, Mathanmohun M. Bacillus-Mediated Silver Nanoparticle Synthesis and Its Antagonistic Activity against Bacterial and Fungal Pathogens. Antibiotics. 2021; 10(11):1334. https://doi.org/10.3390/antibiotics10111334
Chicago/Turabian StyleKabeerdass, Nivedhitha, Ahmed Al Otaibi, Manikandan Rajendran, Ayyar Manikandan, Heba A. Kashmery, Mohammed M. Rahman, P. Madhu, Anish Khan, Abdullah M. Asiri, and Maghimaa Mathanmohun. 2021. "Bacillus-Mediated Silver Nanoparticle Synthesis and Its Antagonistic Activity against Bacterial and Fungal Pathogens" Antibiotics 10, no. 11: 1334. https://doi.org/10.3390/antibiotics10111334
APA StyleKabeerdass, N., Al Otaibi, A., Rajendran, M., Manikandan, A., Kashmery, H. A., Rahman, M. M., Madhu, P., Khan, A., Asiri, A. M., & Mathanmohun, M. (2021). Bacillus-Mediated Silver Nanoparticle Synthesis and Its Antagonistic Activity against Bacterial and Fungal Pathogens. Antibiotics, 10(11), 1334. https://doi.org/10.3390/antibiotics10111334

